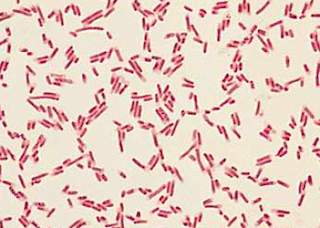

CITROBACTER.
Citrobacter junto con Enterobacter, Klebsiella y Escherichia forma el grupo coloforme de bacterias entéricas.
Son bacterias móviles, fermentadores variables de la lactosa, algunos son
citrato positivos y otros negativos, algunas especies tienen antígenos somáticos
O, flagelar H y de superficie K, lo que hace que den reacciones cruzadas con
otras Enterobacteriaceae.
El género Citrobacter
es un grupo de bacilos gramnegativos aerobios que se encuentran frecuentemente
en el
ü Agua
ü Suelo
ü Comida
ü Y el tracto intestinal de animales y humanos como flora
saprófita.
Son organismos ubicuos y son causa frecuente de infecciones en el hombre,
en especial infecciones urinarias, meningitis neonatal y abscesos cerebrales.
Es uno de los patógenos más importantes en unidades de cuidados neonatales
hospitalarios.
Destruyen las micro vellosidades, formando lesiones muy características
denominadas de adherencia y eliminación.
CASO CLINICO.
Lactante
masculino de 14 meses de edad, originario y residente de Escuinapa, Sinaloa,
con coartación aórtica (CoAo) y comunicación interauricular (CIA) e
interventricular (CIV), estenosis aórtica (EA), conexión anómala parcial de
venas pulmonares izquierdas (CAPVPI) y persistencia del conducto arterioso
(PCA); anomalías que fueron identificadas mediante cateterismo cardiaco.
Hecho
el diagnóstico fue sometido a corrección quirúrgica de sus defectos cardiacos
sin incidentes ni complicaciones transoperatorias.
Después
de la cirugía ingresó a la Unidad de Terapia Intensiva Pediátrica (UTIP) donde
recibió dicloxacilina y amikacina por cuatro días como profilaxis; 12 horas
después de su ingreso fue “extubado” y se le retiraron las aminas.A las 24
horas de su ingreso a la UTIP se le extrae la sonda mediastinal y egresa de la
unidad a los tres días de estancia.
24hrs después manifiesta
taquicardia, taquipnea, fiebre elevada y leucocitosis, con insuficiencia
cardiaca congestiva (ICC).
Se le diagnostica choque
cardiogénico y cae en paro cardiorrespiratorio, por lo que reingresa de
inmediato a la UTIP donde se le maneja con ceftriaxona y amikacina por siete
días. En la unidad persiste con fiebre y una biometría reporta 44,000
leucocitos.
Dos días más tarde el
laboratorio de bacteriología reporta en el hemocultivo la presencia de
Shewanella putrefacciones.
Después se informa también
la presencia en hemocultivo de Citrobacter freundii. Se le mantiene en
tratamiento con meropenem por dos semanas, habiendo mostrado mejoría a partir
del quinto día. A medida en que gradualmente se revertía el estado de choque y
que los hemocultivos fueron negativos, se decidió retirar el antimicrobiano.
Pero poco después manifestó
datos clínicos de respuesta inflamatoria sistémica (RIS) y en el hemocultivo
periférico se encontró Staphylococcus epidermidis, por lo que es tratado con
van-comicina por 10 días.
Con este tratamiento
evolucionó favorablemente con entubación electiva, los leucocitos se normalizaron
y no mostró datos de RIS, por lo que egresa a su domicilio 40 días después de
su internamiento.

No hay comentarios:
Publicar un comentario